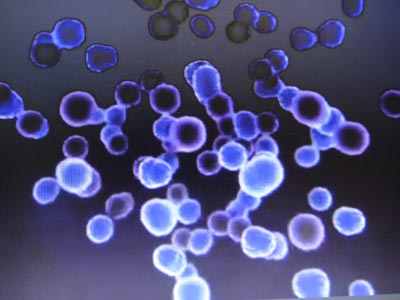

foodforcell.com
AIS: 087 9911816, DTAC: 086 9784166
AIS: 087 9911816, DTAC: 086 9784166
สเต็มเซลล์สร้างเองได้
kulnuch@hotmail.com
| 12-02-2555
| เปิดดู 7619
| ความคิดเห็น 0
วันก่อนเราได้คุยกันไปแล้วเรื่องเซลล์ วันนี้มีเรื่องสเต็มเซลล์มาฝาก
Stem cell สเต็มเซลล์คืออะไร ทำไมถึงได้ดังนัก
เรารู้แล้วว่าเซลล์มีเป็นพันๆ รูปแบบ พันๆรูปร่าง และขนาด
เซลล์แต่ละเซลล์ ทำหน้าที่เฉพาะเจาะจงอย่างใดอย่างหนึ่ง
เช่นเซลล์กล้ามเนื่อ เซลล์หัวใจ เซลล์สมอง
ขณะเดียวกันยังมีเซลล์อีกกลุ่มหนึ่ง ที่เรียกว่า เซลล์ต้นกำเนิด
เซลล์ต้นกำเนิดทุกชนิดจะมีลักษณะพิเศษ 3 ประการคือ
เป็นเซลล์อ่อนที่พร้อมจะเจริญเติบโต แบ่งตัวเองได้
เป็นเซลล์ที่ไม่ได้ทำหน้าที่เฉพาะเจาะจง
แต่เปลี่ยนแปลงเพื่อทำหน้าที่เฉพาะเจาะจงได้
.jpg)
.jpg)
.jpg)
เจ้านี่แหละคือ สเต็มเซลล์
มีนักวิจัยมากมายสนใจในการนำสเต็มเซลล์มาใช้ในการรักษาโรค เช่น
ธาลัสซีเมีย ลิวคิเมีย อัลไซเมอร์ พาร์กินสัน อัมพาตไขสันหลัง กล้ามเนื้อหัวใจขาดเลือด เบาหวาน ให้หายขาดได้
สเต็มเซลล์พบได้ในสายสะดือ เลือด และไขกระดูก เป็นที่ทราบในทางการแพทย์ว่า
สเต็มเซลล์มีความสำคัญ ต่อการสร้างระบบเลือด รวมถึงระบบภูิมิคุ้มกันในร่างกาย
ในผู้ใหญ่จะเป็นสเต็มเซลล์ในไขกระดูกที่มีหน้าที่สร้างเม็ดเลือดต่างๆ รวมถึงเซลล์ที่เกี่ยวกับระบบภูมิคุ้มกัน
การใช้สเต็มเซลล์รักษามีค่าใช้จ่ายที่ค่อนข้างสูงทีเดียว โดยนำสเต็มเซลล์จากร่างกายเรา นำไปเลี้ยงนอกร่างกาย แล้วฉีดกลับเข้าไปใหม่ ไม่สามารถนำสเต็มเซลล์จากที่อื่นมาใช้ได้ เพราะร่างกายจะปฏิเสธ ราคาเข็มละแสน
จะดีกว่าไหมถ้าเราให้ร่างกายเราสร้างสเต็มเซลล์ได้เอง
เพียง เราส่งสารอาหารให้เข้าถึงไมโทคอนเดรียแหล่งต้นกำเนิดพลังงานในเซลล์ให้ได้
ร่างกายเราก็จะตอบแทนเราโดยการสร้างภูมิต้านทาน สร้างภูมิคุ้มกันตัวเอง
สร้างสเต็มเซลล์ที่แข็งแรง เป็นสเต็มเซลล์ ที่ปลอดภัย
ความคิดเห็น
วันที่: Sun Apr 26 02:00:36 ICT 2026
All Comments: 0
Pages: 1/0





